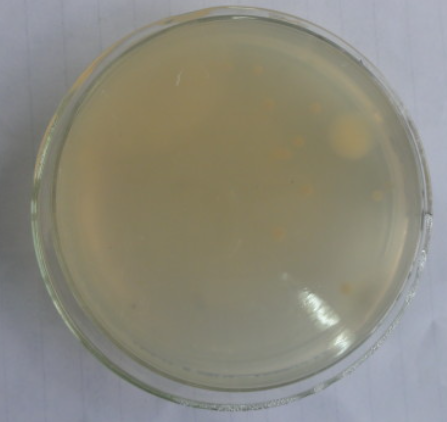
利君股份获得实用新型专利授权:“一种用于气基直接还原热压机的螺旋送料器”

利君股份获得实用新型专利授权:“一种用于气基直接还原热压机的螺旋送料器”
56841
2025年11月15日
证券之星消息,根据天眼查APP数据显示利君股份(002651)新获得一项实用新型专利授权,专利名为“一种用于气基直接还原热压机的螺旋送料器”,专利申请号为CN202422950015.6,授权日为2025年10月31日。

图片来源于网络,如有侵权,请联系删除
专利摘要:本实用新型涉及螺旋送料技术领域,具体公开了一种用于气基直接还原热压机的螺旋送料器,包括顶部安装有进料管且底部设置有出料口的仓筒、安装在仓筒上且与仓筒转动配合的螺旋轴、若干组设置在螺旋轴上且仓筒内的拨料棒、以及安装在仓筒顶部且与螺旋轴传动配合的驱动机构;若干组拨料棒沿螺旋轴的轴向依次设置;所述拨料棒的轴线与螺旋轴的轴线相互垂直。本实用新型能够有效的保证物料处于松散状态并均匀的分部在仓筒内,减小了螺旋轴和缓冲仓的摩擦,进而提高了螺旋轴和缓冲仓的使用寿命。
图片来源于网络,如有侵权,请联系删除
今年以来利君股份新获得专利授权15个,较去年同期增加了36.36%。结合公司2025年中报财务数据,今年上半年公司在研发方面投入了1760.09万元,同比增5.01%。
通过天眼查大数据分析,成都利君实业股份有限公司共对外投资了8家企业,参与招投标项目271次;财产线索方面有商标信息4条,专利信息321条,著作权信息5条;此外企业还拥有行政许可52个。
数据来源:天眼查APP
以上内容为证券之星据公开信息整理,由AI算法生成(网信算备310104345710301240019号),不构成投资建议。